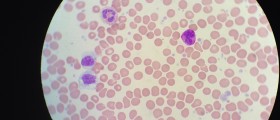

A decreased level of neutrophils in the bloodstream causes a condition called neutropenia. Neutrophils are white blood cells that are also called polymorphonuclear leukocytes (PMN). The condition of neutropenia decreases the ability of the body to fight against infections.
White blood cells are leukocytes, and there are five types of white cells: basophils, lymphocytes (T-cells and B-cells), monocytes and neutrophils, and eosinophils. There are also white blood cells called granulocytes that have microscopic granules with little enzymes, which are components that digest micro-organisms. Neutrophils, eosinophils, and basophils are granulocytes and have non-specific general activity. Neutrophils have enzymes that kill cells and digest microorganisms. And that is a process called phagocytosis. Neutrophils are created in the bone marrow and released in blood and last about 3 days.

The normal number of white cells varies between 4,300 -10,800 cells per microlitre (cubic millimeter -cmm). The WBC is a leukocyte count and is 4.3 x 109 to 10.8 x 109 cells per liter. The % of the WBC in different types of white blood cells is called the WBC differential. (ANC) the count of neutrophils is a product of the white blood cell count (WBC) and the fraction of neutrophils among the white blood cells can be checked with WBC differential analysis. Neutropenia can be severe if the ANC is under 500/microL, moderate if ANC is 500-1000/microL, and light if the ANC is 1000 to 1500/microL,
Neutropenia is diagnosed through a sample of blood from a vein. Perhaps a bone marrow biopsy can diagnose the specific cause of neutropenia. However, some other medical terms should be mentioned.
- Agranulocytosis means having no granulocytes and is a severe neutropenia.
- Leukopenia means a reduced number of white blood cells and granulocytopenia means a decreased number of all the granulocyte-type blood cells.
- Neutrophils have lots of other types of granulocytes and are neutropenia.
The Causes of Neutropenia
Neutropenia can be present in Yemenite Jews, African or Arabic descent. The condition is about decreased production of neutrophils, missing neutrophils after they are produced, or accumulation of the neutrophils out of the way.
There are medical conditions that can cause neutropenia: vitamin deficiencies, infections, cancer chemotherapy or drugs that can damage bone marrow, leukemia, hypersplenism, aplastic anemia, myelofibrosis, radiation therapy, congenital disorders of bone marrow, neutrophils autoimmune, production of neutrophil, Kostmann syndrome, etc...
Neutropenia can cause an increased possibility of getting bacterial infections. The most common type of infection is bacteria on the skin, like staphylococcus aureus or urinary tract and gastrointestinal. Fungal infections are possible in patients who suffer from neutropenia. The infections can stick to certain body parts such as the skin, oral cavity, genital area, etc. However severe and prolonged neutropenia can be spread via the bloodstream to the lungs or elsewhere.
The treatment of neutropenia depends on the underlying cause, the level, and symptoms of the patient and can be: granulocyte transfusions, antibiotics (antifungal medications), to fight infections with all other options, administration of white blood cell growth, intravenous immune globulin or corticosteroid therapy, etc.
- Causes include underproduction (e.g., myelodysplastic syndrome), immune-mediated destruction or redistribution of neutrophils to the endothelium and reticuloendothelial system. Antithyroid, anti-infective and psychotropic drugs, as well as chemotherapy, are causes of drug-induced neutropenia. Transient neutropenia may occur after acute viral infection and typically resolves within 2 weeks. Joint swelling, rash, bony pain, splenomegaly or lymphadenopathy may suggest malignant or autoimmune disease.
- Patients with mild neutropenia are not at substantially increased risk of infection. The neutrophil count should be checked every 3–6 months for at least 1 year to rule out progression to more severe neutropenia.
- emedicine.medscape.com/article/204821-overview
- medlineplus.gov/ency/article/007230.htm
- Photo courtesy of Roberto J. Galindo by Wikimedia Commons: en.wikipedia.org/wiki/Barth_syndrome#/media/File:Neutropenia.JPG

Your thoughts on this
Loading...